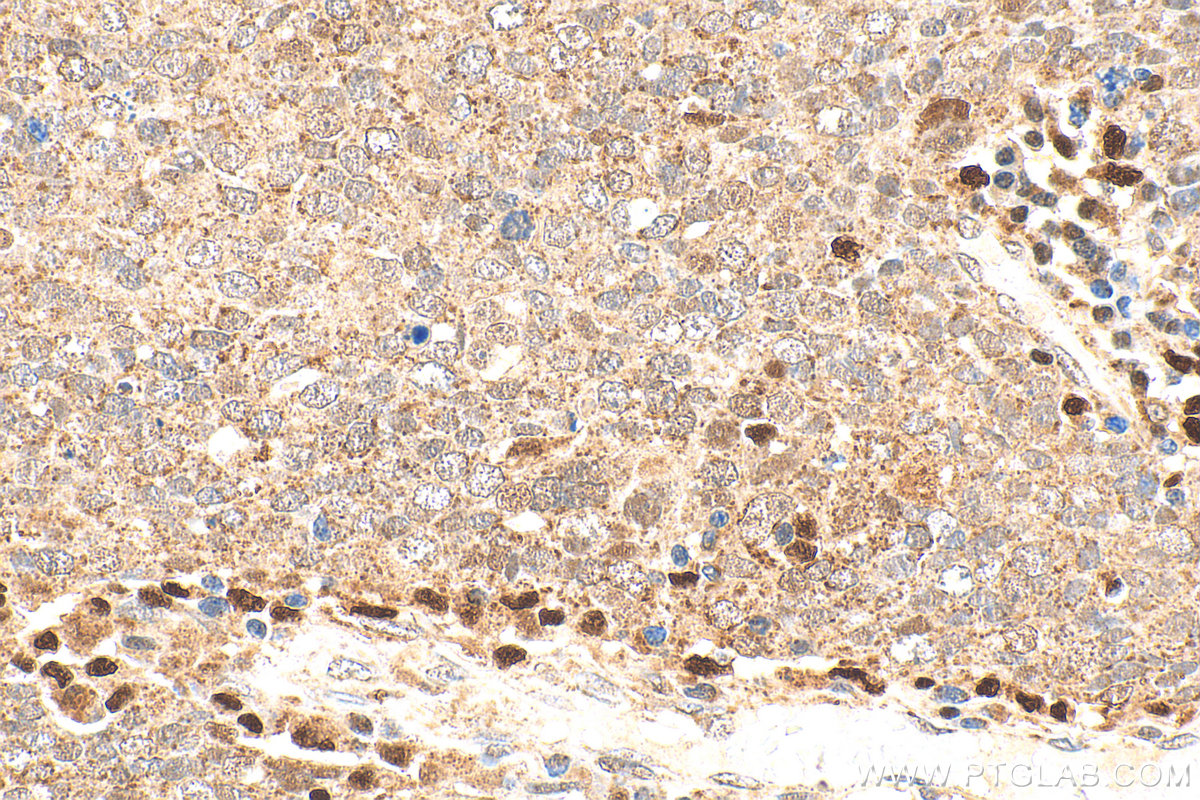
IHC staining of human ovary tumor using 10021-1-Ig

验证数据展示
经过测试的应用
| Positive WB detected in | DU 145 cells, HL-60 cells, K-562 cells, PC-3 cells, human placenta tissue |
| Positive IHC detected in | human lung cancer tissue, human ovary tumor tissue Note: suggested antigen retrieval with TE buffer pH 9.0; (*) Alternatively, antigen retrieval may be performed with citrate buffer pH 6.0 |
| Positive IF/ICC detected in | HepG2 cells |
推荐稀释比
| 应用 | 推荐稀释比 |
|---|---|
| Western Blot (WB) | WB : 1:500-1:1000 |
| Immunohistochemistry (IHC) | IHC : 1:200-1:800 |
| Immunofluorescence (IF)/ICC | IF/ICC : 1:50-1:500 |
| It is recommended that this reagent should be titrated in each testing system to obtain optimal results. | |
| Sample-dependent, Check data in validation data gallery. | |
产品信息
10021-1-Ig targets 5 Lipoxygenase in WB, IHC, IF/ICC, ELISA applications and shows reactivity with human samples.
| 经测试应用 | WB, IHC, IF/ICC, ELISA Application Description |
| 文献引用应用 | WB, IHC, IF |
| 经测试反应性 | human |
| 文献引用反应性 | human, mouse, rat |
| 免疫原 |
Peptide 种属同源性预测 |
| 宿主/亚型 | Rabbit / IgG |
| 抗体类别 | Polyclonal |
| 产品类型 | Antibody |
| 全称 | arachidonate 5-lipoxygenase |
| 别名 | ALOX5, 5 LO, 5 LOX, 5-lipoxygenase, 5LO |
| 计算分子量 | 674 aa, 78 kDa |
| 观测分子量 | 70-78 kDa |
| GenBank蛋白编号 | BC130332 |
| 基因名称 | 5 Lipoxygenase |
| Gene ID (NCBI) | 240 |
| RRID | AB_513237 |
| 偶联类型 | Unconjugated |
| 形式 | Liquid |
| 纯化方式 | Protein A purification |
| UNIPROT ID | P09917 |
| 储存缓冲液 | PBS with 0.02% sodium azide and 50% glycerol, pH 7.3. |
| 储存条件 | Store at -20°C. Stable for one year after shipment. Aliquoting is unnecessary for -20oC storage. |
背景介绍
ALOX5(arachidonate 5-lipoxygenase) is also named as LOG5, 5-LO and belongs to the lipoxygenase family. It catalyzes the first step in leukotriene biosynthesis, and plays a role in inflammatory processes. It is a 78 kDa iron-containing enzyme that translocates from the cytosol to associate with FLAP, and converts arachidonate in two steps into the unstable intermediate LTA4. It is essential for cysteinyl-leukotriene (cys-LT) production, critical mediators in asthma(PMID:12911785).
实验方案
| Product Specific Protocols | |
|---|---|
| IF protocol for 5 Lipoxygenase antibody 10021-1-Ig | Download protocol |
| IHC protocol for 5 Lipoxygenase antibody 10021-1-Ig | Download protocol |
| WB protocol for 5 Lipoxygenase antibody 10021-1-Ig | Download protocol |
| Standard Protocols | |
|---|---|
| Click here to view our Standard Protocols |
发表文章
| Species | Application | Title |
|---|---|---|
Front Pharmacol Fenofibrate suppresses corneal neovascularization by regulating lipid metabolism through PPARα signaling pathway | ||
Int Immunopharmacol The ALOX5 inhibitor Zileuton regulates tumor-associated macrophage M2 polarization by JAK/STAT and inhibits pancreatic cancer invasion and metastasis | ||
Biochem Pharmacol PPARα agonist WY-14,643 induces adipose atrophy and fails to blunt chronic ethanol-induced hepatic fat accumulation in mice lacking adipose FGFR1. | ||
J Biol Chem Inhibition of 5-lipoxygenase selectively triggers disruption of c-Myc signaling in prostate cancer cells.
| ||
PLoS One MK591, a Second Generation Leukotriene Biosynthesis Inhibitor, Prevents Invasion and Induces Apoptosis in the Bone-Invading C4-2B Human Prostate Cancer Cells: Implications for the Treatment of Castration-Resistant, Bone-Metastatic Prostate Cancer. | ||
Exp Cell Res Lipoxin A4 and its analog attenuate high fat diet-induced atherosclerosis via Keap1/Nrf2 pathway. |